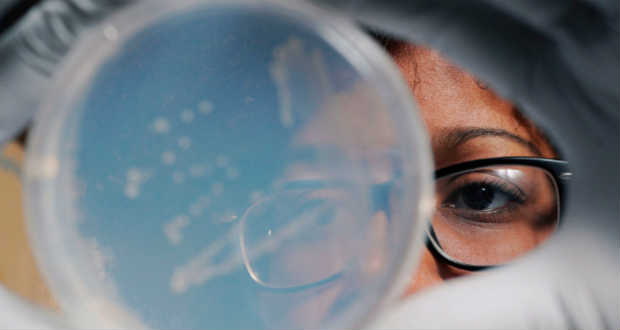
Új, rendkívül ellenálló gonorrheakórokozókat fedeztek fel

Balaton-átúszás – Megrendezik vasárnap a versenyt
Vasárnap megrendezik a 35. Balaton-átúszást – a főszervező Budapest Sportiroda (BSI) tájékoztatása szerint.

Vasárnap megrendezik a 35. Balaton-átúszást – a főszervező Budapest Sportiroda (BSI) tájékoztatása szerint.

Az Arsenal labdarúgócsapata bejelentette, hogy német kapitányának visszavonulása nem jelenti azt, hogy a klubot elhagyja, ugyanis a jövőben az Ágyúsok utánpótlás akadémiájának vezetőjeként tevékenykedik a londoniaknál.

A végéhez közeledik a Szépművészeti Múzeum Román csarnokának felújítása, az átfogó rekonstrukció után pedig jövő ősszel vehetik újra birtokba a látogatók a múzeumot.

A ZALAERDŐ Zrt. fotópályázatot hirdet, melynek témája a Kárpát-medencei tavaszi és nyári erdő.
Új, minden kezelésnek ellenálló gonorrheakórokozók megjelenésére figyelmeztetett az ENSZ Egészségügyi Világszervezete (WHO) pénteken.

A nemzetpolitikai alapú befektetések nem kidobott pénzek, hanem nagyon is megtérülő invesztíciók nemcsak erkölcsi, nemzeti identitáserősítő tekintetben, hanem egyre inkább gazdaságilag is – hangoztatta Grezsa István kormánybiztos csütörtökön Felsőszinevéren, a XXV. Kárpátaljai Nyári Szabadegyetem gazdasági vitadélutánján.

A belga közlekedési miniszter javaslata alapján 100 eurós büntetést kellene fizetniük azoknak, akik a vasútállomásokon hagyják csomagjaikat – közölte a La Libre Belgique című belga napilap.

A lélek ünnepe 2017 c. antológiánk megjelentetésével kapcsolatos információk:

Augusztus végéig több mint ezer véradást szervez országszerte a Magyar Vöröskereszt és az Országos Vérellátó Szolgálat.

Négy magyar egyetemista találmánya képviseli hazánkat a Microsoft Imagine Cup innovációs versenyének nemzetközi döntőjén idén júliusban, Seattle-ben.
End of content
End of content